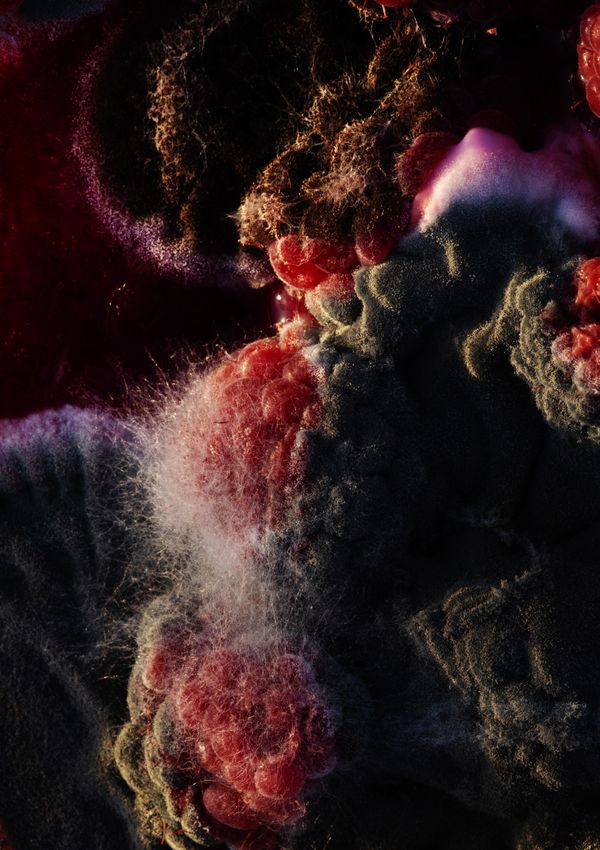

Sunset Sour
-
Dates2023 - 2026
-
Author
Sunset Sour is a tale of decadence, of excess, and of ineluctable decay. In my latest long-term project I capture a society at a tipping point, in a moment of excess derived from an attempt to hold the passing of time ...
Sunset Sour is a tale of decadence, of excess, and of ineluctable decay. In my latest long-term project I capture a society at a tipping point, in a moment of excess derived from an attempt to hold the passing of time, to refuse the fleeting nature of human flesh and human life, giving in to a fantasy of control, power, and accumulation.
As in a Greek tragedy, the end is already written, and any action taken against one’s destiny will only viciously circle one back to its path, destruction in its wake. The ruins, the scars, the wrinkles, the fading paint, are many omens of a looming collapse—a prospect that becomes highly detrimental on a societal scale. Yet, Sunset Sour is a celebration of how the body, as it ages, does not become less, but on the contrary magnificent in its many excesses: excess of freckled and tanned skin, of shimmery clothing, of feathery processed hair, of surgical interventions and sharp nails. Despite the slipping of control over one’s flesh, the bodies remain decidedly brazen, idle and sun-drenched.
Capricious and egoistic, the sun indifferently warms the flesh or burns the skin. It gives light, heat, beauty, and hope, only to take it all away. As an inevitable downfall incrementally takes hold, this body of work would like to offer slivers of an ambivalent suspended time, inviting us to savour the sun and the skin.